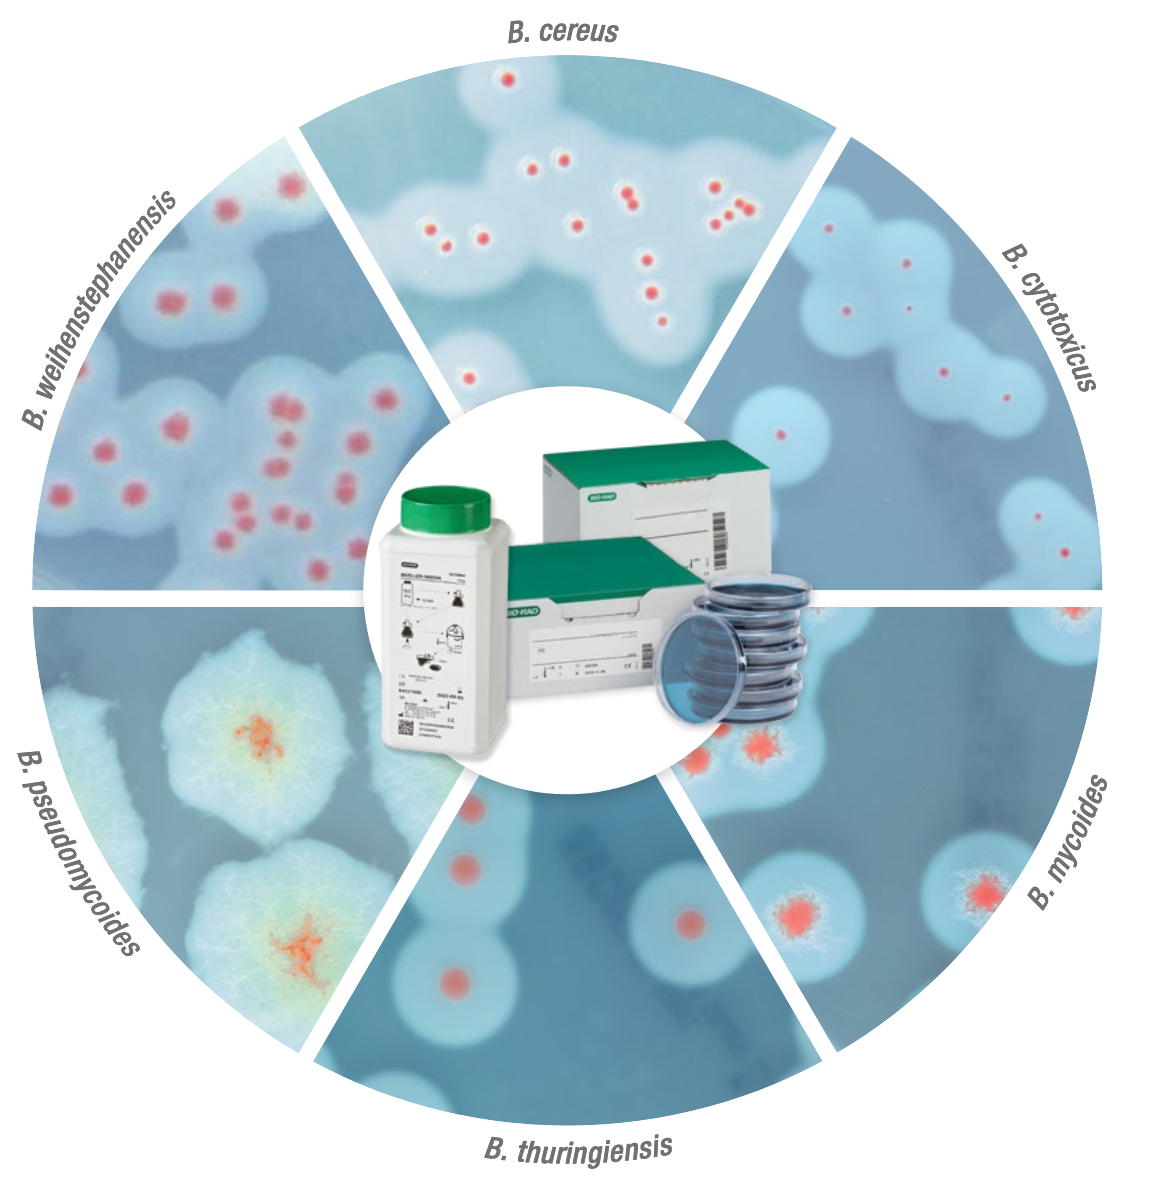
Analysemetoder og mikrobiologi

Produktansvarlig Hygienekontroll
LABOLYTIC AS


Et Norsk selskap, med kontor og lager i Trondheim. Vi leverer analysemetoder, instrumenter og utstyr til kvalitetskontroll og hygienekontroll innen bl.a. matindustri, havbruk, laboratorier og renhold.

Algekontroll i Ofoten, med vår algesensor
Praktiske små måleinstrumenter